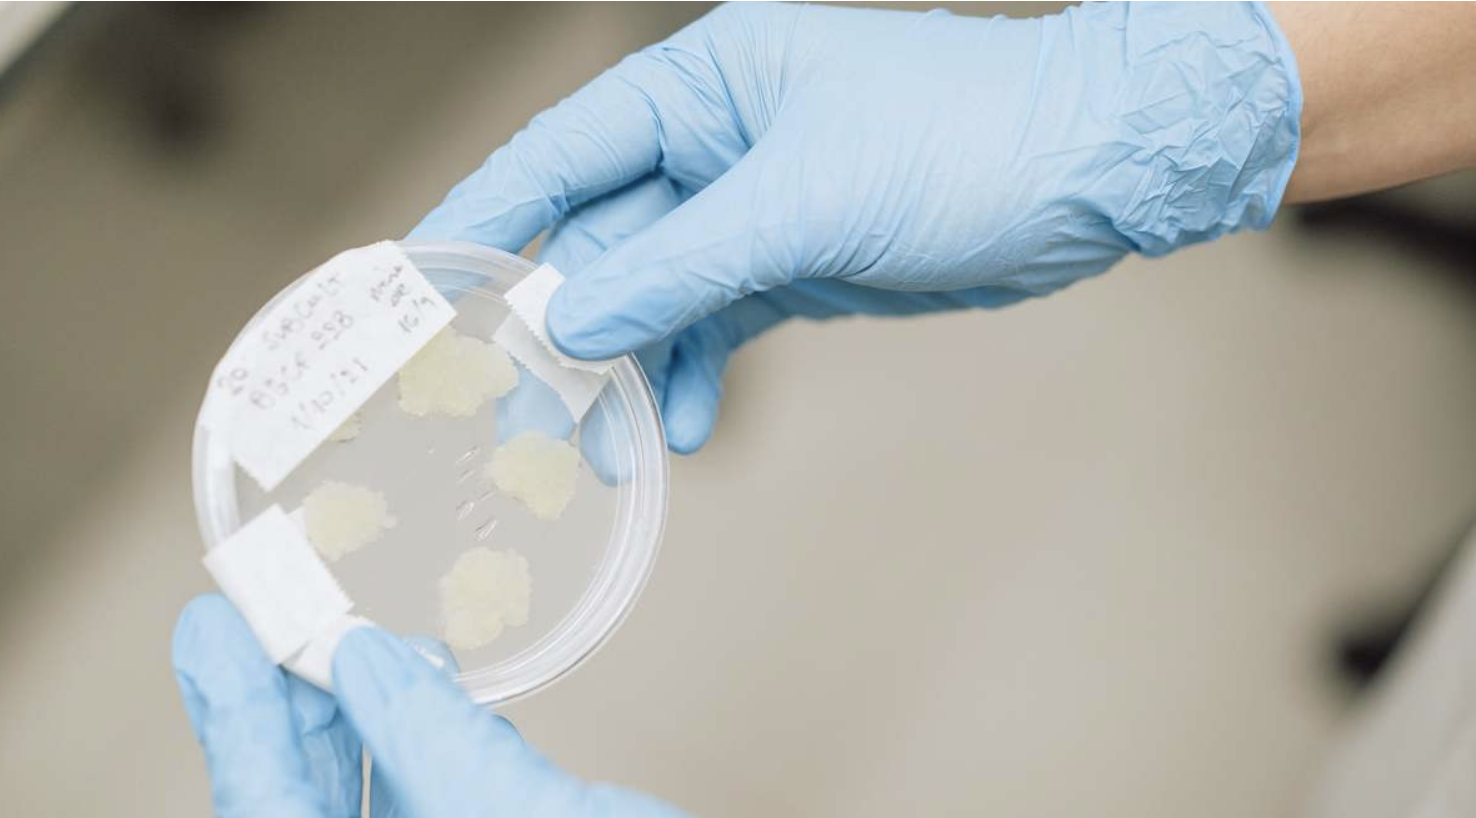

Impulsamos la innovación en la industria agroalimentaria
Impulsamos la innovación en la industria agroalimentaria abordando retos globales y locales, creando un ecosistema que genere valor y progreso.
Venture
Building
Creamos startups con innovaciones disruptivas, que transforman el sector y que están alineadas con la visión estratégica de Pascual.
Venture
Capital
Realizamos inversiones en startups con el objetivo de incorporar nuevas tecnologías y generar nuevas oportunidades estratégicas.
Open
Innovation
Abordamos los retos de Pascual a través de colaboraciones estratégicas con startups.
Acceleration
Program
Aceleramos startups a través de nuestro programa Mylkcubator.
Invertimos en tu startup y te ayudamos hasta donde tú necesites:
Estrategia
Visión, conocimiento del mercado, plan estratégico, objetivos…
Gestión de personas
Selección, formación, RR. HH
Gobierno
En algunas nos sentaremos en el consejo, en otras no. Pero sí que te ayudaremos a prepararlos.
Operaciones
Te podemos ayudar en ámbitos de tu día a día que necesites apoyo. Desarrollos de MVP y estrategias de escalado.
Network
Te conectamos con inversores y ayudamos en el fundraising. Te conectamos con potenciales clientes y nuestra amplia red de partners, como centros tecnológicos, universidades, aceleradoras, etc.
Marketing y comunicaciones
Te podemos dar mucha visibilidad.
Servicios
Te ayudamos en la parte legal, financiera, fiscal y administración.
Instalaciones
Espacio de trabajo, acceso a tecnologías y experiencia en I+D de Nutrición y Salud.
Nuestras verticales de búsqueda
Nuestras verticales de búsqueda
Ag Tech
Robótica agrícola
Explotaciones indoor y nuevos modelos de cultivo
Marketplaces agrícolas
Biotecnología agrícola
Alimentación animal
Food Science
Startups de gran consumo (CPG)
Bebidas y refrescos
Ingredientes funcionales
Food service
Restaurantes virtuales
Robótica para foodservice y hostelería
Soluciones de pago (TPV / ePOS)
Cocinas en la nube
Consumer tech
Electrodomésticos y menaje de cocina
Experiencias gastronómicas
Sistemas de recomendación
Recetas
Delivery
Delivery de restaurantes
Nuevos modelos de retail
Discovery box
Q-commerce
Robótica para reparto y última milla
Portfolio
Crean y operan marcas de alimentación co-diseñadas con creadores de contenido, llevando food + cultura contemporánea al gran público.
Plataforma SaaS que ayuda a restaurantes a digitalizar facturas, monitorizar costes en tiempo real y mejorar márgenes gracias a IA y OCR.
Equipos de purificación y mineralización de agua que combinan sabor, comodidad y sostenibilidad.
Usan fermentación de precisión para producir proteínas de la leche humana, el gold standard de la nutrición funcional.
*We Tried, We Learned, We Grew
Descubre
Mylkcubator

Programa de incubación global para acelerar startups que trabajan en tecnologías disruptivas en nuestra cadena de valor.
El equipo

Gabriel Torres Pascual

Cristina Pérez Santos

Carmen Lendoiro Boquete

Alba Bernardino Cuesta

Álvaro Valdés Penalva

Jaime Puelles
Impulsamos
innovación
© 2026. Pascual Innoventures